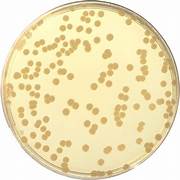

Indicação de uso
O Ágar PCA (Plate Count Agar) ou Ágar Contagem de
Placas é usado para obter contagens
de placas microbianas de leite e produtos lácteos, alimentos, água e outros
materiais de importância sanitária. O ágar PCA é recomendado em métodos padrão
para contagem pela técnica de pour plate, spread plate e filtração de membrana
para contagem de bactérias heterotróficas em placas. É o meio indicado no Standard
Methods for the Examination of Water and Wastewater, citado na farmacopeia
americana e farmacopeia brasileira como opção de ágar para contagem em água. Ele
é recomendado para obter contagens de placas em amostras de leite e outros
produtos lácteos e também pode ser usado para determinar a qualidade sanitária
de alimentos, água e outros materiais.
- Peptona de caseína - 5,0 g
- Extrato de levedura - 2,5 g
- Glicose ou dextrose - 1,0 g
- Ágar - 15,0 g
A peptona de caseína fornece os aminoácidos e outras substâncias nitrogenadas complexas necessárias para sustentar o crescimento de bactérias. O extrato de levedura fornece principalmente vitaminas do complexo B e a glicose ou dextrose é uma fonte de energia. Agar é o agente solidificante.
pH 7,0 ± 0,1. Esterilizar em autoclave usando ciclo validado.
O preparo do meio deve seguir as instruções do fabricante.
O Ágar PCA tem alta concentração de nutrientes, sendo adequados para isolamento geral e enumeração de bactérias heterotróficas ou copiotróficas (bactérias que consomem grande quantidades de carbono). A temperatura e tempo de incubação são aspectos críticos para os testes microbiológicos da água, devido aos tipos de micro-organismos encontrados nos sistemas de água. Incubações a baixas temperaturas (por exemplo, de 20 °C a 25 °C ou de 25 °C a 30 °C) por períodos mais longos, por pelo menos quatro dias, podem levar a recuperações mais altas de micro-organismos, do que as temperaturas clássicas. Os meios com baixa quantidade de nutrientes requerem períodos de incubação mais longos (pelo menos cinco dias), pois esses meios promovem crescimento mais lento. Mesmo aqueles com alta concentração de nutrientes podem algumas vezes resultar em alta recuperação microbiana por longos períodos de incubação e temperaturas mais baixas. A decisão sobre o tipo de meio de cultura e a temperatura de incubação para se testar um sistema de purificação de água deve ser baseada em estudos comparativos de cultivo usando um microbioma nativo dos sistemas de purificação da água em análise.
Micro-organismos Indicados para o Teste de Grow Promotion
Para verificar a esterilidade dos meios de cultura, colocá-los em incubação por, no mínimo, 72 horas, na temperatura adequada. Não deve haver crescimento microbiano ou alteração de cor.
As farmacopeias não apresentam as cepas para Grow Promotion, nesse caso pode-se utilizar os micro-organismos indicados no certificado do fabricante:
Para promoção de crescimento
Staphylococcus aureus ATCC 25923
Bacillus subtilis ATCC 6633
Escherichia coli ATCC 25922
Outros micro-organismos podem ser inoculados, de acordo com a metodologia usada.
Inocule no meio pequeno número (não mais de 100 UFC) do micro-organismo teste. Incubar na temperatura e tempo especificados no ensaio de pesquisa do micro-organismo de interesse.
Realizar GP em cada novo lote de meio de cultura adquirido pronto para uso ou preparado no laboratório, em paralelo com um meio de cultura previamente aprovado.
Os micro-organismos devem ser rastreáveis de uma Cultura de Coleção de Referência e devem estar em não mais do que 5 passagens da Cultura de Referência. Compare o crescimento no novo meio de cultura com o crescimento no meio previamente aprovado. O crescimento deve ser “comparável”. Não existe na USP a definição de quantidade do que é “comparável” Em paralelo realizar o controle do inóculo em ágar não seletivo: deve haver ≤ 100 UFC. E se não houver lote previamente aprovado? Considere adicionar outros Analistas do Laboratório. Use um número significativo de replicatas. A média das médias pode ser considerada como ponto de referência. Essas recomendações servem para a promoção de crescimento de qualquer meio.
Fontes:
United States Pharmacopeia 43ª ed. 2020
Difco
& BBL Manual - Manual of Microbiological Culture Media – Second Edition
Farmacopeia
Brasileia 6ª ed. 2024
Standard Methods for the Examination of Water and
Wastewater 23ª ed.